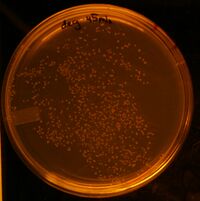
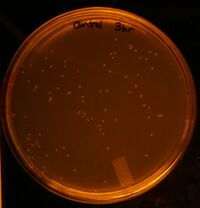

Berk2010-Conor (July)
Conor McClune 17:16, 30 July 2010 (EDT)
Miniprep of iGEM10_004 Eco/Bam Transfer
Miniprepped clones 4B, 4F, 6D and 6G (6G looks best on Col PCR)
Assembly of iGEM10_006
Digestion
- iGEM10_005 is already digested and gel purified
- standard Xho/Bgl digest of the 4 above minipreps of iGEM10_004
- expected fragments: 4841(desired fragment) and 1475
- Gel photo:
All lanes are incorrectly sized
Transformation of iGEM10_103 (identical to iGEM10_006
- Recipe: 100uL JTK030 cells, 15uL KCM, 2uL miniprepped DNA
- let sit on ice for 2 minutes
- heat shocked for 90 seconds
- let sit on ice for 2 minutes
- added 100uL 2YT
Conor McClune 14:20, 29 July 2010 (EDT)
Degradation Assay Results
Plate Photos
Lysed Cells - Time points: 15min, 30min, 45min, 1hr, 1.5hr, 2hr, 2.5hr, 3hr

Control - Time points: 0hr, 1hr, 2hr, 3hr

Analysis
The results to not seem too accurate; at least, there is a fair amount of noise. The control should have had a higher transformation rate, not lower. Both samples do not display a smooth transition over time.
Suggestions for next time:
- mix all competent cells into a big batch, add H20 and KCM, THEN aliquot into zymo products
- Dilute the DNA by 10 or more in LB, then add to both cultures, to account for the pipetting differences that will occur between samples when dealing with such small quantities
- create dilutions of transformed cells after plating 70uL: 1/10th, 1/100th, 1/1000th - this will make colony counting easier and much more accurate
Restriction Digest iGEM10_013
- Digested all 7 minipreps (#1-6,8) with Eco/Bam (standard digestion)
- incubated for 45 minutes at 37*C
- expected fragment sizes: 6213, 2736
- results:
- in lanes 1 and 5, the larger bands are barely visible (in 5 you can also see the parent vector)
- if they exist, the bands in the other lanes are too faint to see
- clones 7, 3, and 1 are cotransformed
Picking Colonies/ Colony PCR of Eco/Bam Transfers of iGEM10_004 #4 and #6
- picking 8 colonies from each plate
- dipping each colonies into two Colony PCR master mixes
- igemTen010 + TH313 - to test for correct vector
- ca998 + igemTen008
- note: colony E from the Eco/Bam of iGEM10_006 #6 was accidentally picked from iGEM10_006#4
PCR Gel Results
- expected sizes:
- ca998+igemTen008 - 1135bp
- lanes 1-8: iGEM10_004 #4
- lanes 9-16: iGEM10_004 #6
- igemTen010 + TH313 - 1808bp
- lanes 17-24: iGEM10_004 #4
- lanes 25-32: iGEM10_004 #6
- ca998+igemTen008 - 1135bp
Only one good colony: iGEM10_006 #6-G
Analytical PCR of iGEM10_003
Run on 4k55:
| Well | Colony | Fwd Oligo | Rev Oligo | Expected size | Acceptable? |
| 1 | 1 | ca56 | igemTen020 | 2619 | yes |
| 2 | 2 | ca56 | igemTen020 | 2619 | yes |
| 3 | 3 | ca56 | igemTen020 | 2619 | yes |
| 4 | 4 | ca56 | igemTen020 | 2619 | yes |
| 5 | 5 | ca56 | igemTen020 | 2619 | yes |
| 6 | 6 | ca56 | igemTen020 | 2619 | yes |
| 7 | 8 | ca56 | igemTen020 | 2619 | yes |
| 8 | 2 | igemTen035 | g00101 | 3969 | yes |
| 9 | 3 | igemTen035 | g00101 | 3969 | yes |
| 10 | 4 | igemTen035 | g00101 | 3969 | yes |
| 11 | 5 | igemTen035 | g00101 | 3969 | yes |
| 12 | 6 | igemTen035 | g00101 | 3969 | yes |
| 13 | 8 | igemTen035 | g00101 | 3969 | yes |
| 14 | 1 | igemTen035 | g00101 | 3969 | yes |
Conor McClune 14:26, 28 July 2010 (EDT)
Degradation Assay
Overview:Add 1uL of atc to each 1mL sample of cells. Let cells lyse for an hour. Add 1uL of DNA. At each of the following intervals: 15min, 30min, 45min, 1 hour, 1.5, 2, 2.5, 3, remove 200uL of DNA, spin down, and zymo supernatant. After you have all your zymo'd samples, plate on Amp.
Cells used: JTK030 cells transformed with the completed transposase part iGEM10_020 (note: this part is not going to be turned on, we are only using a transformed strain to ensure this assay is under the same conditions as the transposase assay.
Plasmid used: Bca9145 in pBca1144 (an RFP)
Control: I will incubate 1uL of the same cells, without ATC, simultaneously, then draw out 200uL of cells at 0,1,2 and 3 hours to zymo and plate on AMP. This will allow us to see any natural degradation that is unrelated to endonucleases or other products of lysis.
Procedures:
1:30 1mL cells placed on incubator as a control. 2.5uL of ATC added to 2.5mL cells (from the same colony pick) and placed on the incubator.
2:30 Added 1uL of DNA to the control and 2.5uL DNA to the lysing cells. Solutions are swirled. 200ul removed from control tube and zymo'd (note: 90 sec dry spin cut short
2:45 Removed and zymo'd 200uL degredation culture
3:00 Removed and zymo'd 200uL degredation culture
3:15 Removed and zymo'd 200uL degredation culture
3:30 Removed and zymo'd 200uL degredation culture and 200uL of control culture
4:00 Removed and zymo'd 200uL degredation culture
4:30 Removed and zymo'd 200uL degredation culture and 200uL of control culture
5:00 Removed and zymo'd 200uL degredation culture
5:30 Removed and zymo'd 200uL degredation culture and 200uL of control culture
Transformation
- Created 4 cell mixtures: 150uL TGI cells mixed with 50uL water and 30uL KCM.
- 70uL of this cell mixture was added to each of the 8.5uL Zymo products
- kept on ice for 5 -10 minutes
- heat shocked for 1.5 min
- replaced on ice for 1 min
- added 2yT and incubated for 1hr
- plated 70uL of each culture on an Amp plate
Eco/Bam Transfer of iGEM10_006 to KA (3rd Attempt)
Digestion
- Recipe: 7uL DNA, 1uL NEB2, 1uL Eco, 1uL Bam
- Digested 11:50-12:50
Gel Analysis
Lane 1: the above digestion of iGEM10_006 Expected Sizes:5734, 2868
Lane 2: my gel purified version of an older iGEM10_006 Eco/Bam digest Expected Size:5734

It seems that my miniprep has gone bad. Some endonucleases must have survived the miniprep and chewed up the DNA
Eco/Bam Transfer of iGEM10_004 into CA
Digestion
- standard Eco/Bam digestion of all four minipreps of iGEM10_004 (#1,2,4,6)
- incubated from 2:30-3:30
Gel Purification
- expected sizes: 3580, 2736
- lane 3 (colony #4) looks ok
- lane 4 (colony #6) looks best
- lanes 1,2 look degraded
Ligation
- ligated iGEM10_004#4 and iGEM10_004#6 into pMLL9-CA
- Standard ligation.
- Left at room temp from 4:30-6:00
Transformation
- Cell mixture: 100uL JTK030 cells, 50uL H20, 30uL KCM
- added 70uL of cell mixture to each of the two ligations
- standard heat shock/1hr rescue
- plated 70uL on CA plate
Miniprep of iGEM10_01
- The colony PCR failed for all 8 picked colonies (no visible bands)
- colony #7 was cotransformed
- I will miniprep all other colonies 1-6,8
ASW Choano Culture
The culture spilled a little in the drawer, so I added 5uL fresh ASW and 100uL of dead E. coli for food
Conor McClune 14:40, 27 July 2010 (EDT)
Miniprep of Eco/Bam of iGEM10_006
Decided to miniprep colonies 1,2,3&5, but the cultures of colonies 2 & 3, spilled. Thus I am miniprepping all the other cultures (1,4-8). I also added 2uL fresh KA LB to cultures 2 &3, in case the other cultures are not as good.
Confirmation via Analytical PCR
- each of these are colonies of iGEM10_006 in (hopefully) pMLL6-KA
| Well | Part | Colony | Fwd Oligo | Rev Oligo | Expected Size | Acceptable? |
| 1 | iGEM10_006 | 1 | ca998 | igemTen008 | 3289 | no |
| 2 | iGEM10_006 | 4 | ca998 | igemTen008 | 3289 | maybe, but very faint |
| 3 | iGEM10_006 | 5 | ca998 | igemTen008 | 3289 | maybe, but very faint |
| 4 | iGEM10_006 | 6 | ca998 | igemTen008 | 3289 | maybe, but very faint |
| 5 | iGEM10_006 | 7 | ca998 | igemTen008 | 3289 | no |
| 6 | iGEM10_006 | 8 | ca998 | igemTen008 | 3289 | maybe, but very faint |
| 7 | iGEM10_006 | 4 | TH313 | igemTen010 | 1808 | no |
| 8 | iGEM10_006 | 6 | TH313 | igemTen010 | 1808 | yes |
| 9 | iGEM10_006 | 7 | TH313 | igemTen010 | 1808 | yes |
| 10 | iGEM10_006 | 8 | TH313 | igemTen010 | 1808 | yes |
- Run on program 4K45
Confirmation via Restriction Mapping
I digested each of these minipreps with Xho and Bgl and incubated from 11:40-12:50
- expected fragments: 6995, 1607
Assembly of iGEM10_007
Picking Colonies of iGEM10_013
- Picking 8 colonies
- Colony PCR: ca56 and igemTen020 (expected size 2619)
- clones 1,3,7 are cotransformed
Conor McClune 14:25, 26 July 2010 (EDT)
Miniprep iGEM10_012
All 5 colonies looked good on the colony PCR, so I will miniprep the first 4.
Assembly of iGEM10_013
Digestion
Digested all four minipreps of iGEM10_012 (colonies #1-4). This digestion will also serve as a mapping analysis.
- Recipe: 4uL H20, 1uL NEB2, 1uL Xho, 1uL Bgl, 4uL DNA
- incubated from 11:55-12:55
Ran digestions on gel:
- desired fragment: 6139
- other fragment: 1607

Colonies 1,2 and 4 are definitely good, while colony 3 might be. I gel purified the desired 6kb band of colony 1.
Ligation
- recipe: 6uL H20, 1uL T4 buffer, 1uL ligase, 1uL
- incubated at room temp from 1:45-2-18
Transformation
- Cell mixture: 100uL JTK030 cells, 50uL H20, 30uL KCM
- added 70uL of this cell mixture to my entire ligation mixture
- standard heat shock transformation
- rescued from 2:25-3:25
- accidentally plated most of solution on KA instead of CA
- used spreader to transfer cells onto correct plate, also added the cells remaining in the tube.
Creation of Choano ASW culture without bacteria
- added 15uL 1000 Kanamycin to 15uL artificial sea water
- aspirated media from the Mx2 culture
- poured the Kan ASW into the culture dish
- added 100uL 2741 - 8043 cells for food
Picking Colonies for iGEM10_006 Eco/Bam Transfer
- Picked 8 colonies
- Colony PCR:
- colonies 1-8 : ca56 + igem004
- colonies 1-5 : igem010 + TH313 (ran out of MM for last 3 colonies)
Gel Results
Expected sizes:
- lanes 1-8 :1859
- lanes 9-13: 1808
- colonies 1,2,3,5 seem good, though none of the colonies reacted with the ca56/igemTEn004 PCR mix
- I will miniprep these four colonies
- none of the colonies were cotransformed (or course)
Conor McClune 13:52, 26 July 2010 (EDT)
Assembly of iGEM10_012
Picking Colonies
- Picked 5 colonies
- Swiped on AKC plate to check for cotransformation
- dipped in Col PCR MM containing the oligos ca998 and igemTen18
- expected size: 1376bp
Gel Results

All five colonies look good.
Eco/Bam Transfer of iGEM10_006 (2nd attempt)
Ligation
- used the Eco/Bam version of iGEM10_006 that I digested and gel purified yesterday
- recipe: 5uL water, 1uL ligase buffer, 1uL ligase, 1uL digested pMLL6-KA vector, 2uL Eco/Bam digested part
- incubated at room temp from 8:15-8-45pm
Transformation
- Cell mixture: 100uL JTK030 cells + 20uL KCM
- I added 80uL of this mixture to my ligation mixture
- let sit on ice for 5 minutes
- heat shocked for 90 seconds
- let sit on ice for 1min
- added 100uL 2YT
- rescued from 8:55-
Conor McClune 15:47, 23 July 2010 (EDT)
Restriction mapping of iGEM10_006 Eco/Bam
- digested all 5 minipreps with Eco/Bam
- 4uL DNA, 4uL H20, 1uL each enzyme, 1uL NEB2
- incubated 11:15-12:12
Assembly of iGEM10_012
Digestion
Digested iGEM10_010 with lefty MM and iGEM10_011 with righty MM
- incubated 11:25-12:25
2:00-
- expected sizes:
- 010:
- 2912, 1064
- 011:
- 4834, 1475
- 010:
Ligation
I did a standard ligation recipe and let it sit from 4:00-4:30
Transformation
- Cell mixture: 100ul JTK030 cells with 20ul KCM
- Combined 70uL ligation mixture with ligation mixture
- heat shocked
- rescued for 1.5 hours
- plated entire solution onto KA plate
Repicking Colonies of iGEM10_006 Eco/Bam Transfer
I may have destroyed my DNA samples by vortexing during the wrong stage of miniprepping, so I am going to grow them up again. There are only 5 colonies, and we know from the last colony PCR that they are all on the correct vector. This time I shall run a Col PCR that will check the part.
- Repicking all 5 colonies
- running col PCR with oligos: ca998 and igemTen004
Gel Results
Expected size: 1859

These bands are all too short. I will have to redigest and retransform.
Gel Analysis of iGEM10_006 Eco/Bam digest
Expected size: 5925

There are no visible bands. This may have been a faulty digestion and could possibly be the source of the error. I will redigest it
Re-Eco/Bam Transfer of iGEM10_006 to KA
- Did a standard Eco/Bam digestion recipe for iGEM10_006.
- Incubated from 4:06-4:45. Gel purified the larger band.
Conor McClune 17:24, 22 July 2010 (EDT)
Picking Colonies/ Colony PCR for iGEM10_007
- Picking 24 colonies
- colony PCR's:
- ca56 + igemTen004
- checks for iGEM10_001 and sbb04 (left side of iGEM10_007)
- expected size: 2045
- ca56 + igemTen004
- all lanes are empty
Conor McClune 13:52, 21 July 2010 (EDT)
NH4 Toxicity Assay
Setup (completed 9:15am)
- made 4 aliquots of 3mL of healthy MbFb (2 days after 1:15 split)
- placed these in the following conditions:
- 25*C
- 37*C
- 37*C with 10mM NH4
- 37*C with 1mM NH4
1 Hour Count (10:15am)
- the PI stain seems to be dead, because I can see no fluorescence, including background. Thus I will only take pictures and qualitative observations
- increased swimming in all three 37*C samples, otherwise, no difference between samples
4 Hour Observations (1:15 pm)
- choanos are still much more active at 37*C than at 25*C
12th Hour (9:15pm)
Choanos are still active in all wells. I took a hemocytometer count of the cells in each wells. However, I did not dilute the first two cultures (which were denser than I expected) and counting took longer than 30 minutes (the usual time before formaldehyde begins causing choanos to lyse). Thus, the counts for the last two cultures may be inaccurate.
Choano Counting Procedure:
- scrape choanos
- remove 200uL of each of the 4 cultures to 1.5mL tubes
- add 1uL formaldehyde to each tube, shake
- pipette 10uL of each tube into hemocytometer
- wait 10 minutes for choanos to sink
- count 4 quadrants and average:
Note: due to time crunch, I diluted the two NH4 samples 1:10 in order to speed up the process
| ' | Dilution | 1 | 2 | 3 | 4 | Average | Cell density (cells/mL) |
| 25*C control | n/a | 242 | 309 | 249 | 270 | 267.5 | 2675000 |
| 37*C control | n/a | 284 | 321 | 290 | 274 | 292.25 | 2922500 |
| 37*C 10mM NH4 | 1 :10 | 27 | 31 | 29 | 6 | 23.25 | 2325000 |
| 37*C 1mM NH4 | 1 :10 | 17 | 30 | 17 | 24 | 22 | 2200000 |
At 9:30, I had scraped the cells to do the above counts, so by 10:30 the percentage of choanos attached the the bottom had peaked. I aspirated all the media from each of the 4 cultures and replaced it with 3mL choano media.
25th Hour
I removed 100uL of each culture, diluted it 1:4 and counted it on the hemocytometer. This should be a more accurate count than the one at 12 hours.:
| ' | Dilution | 1 | 2 | 3 | 4 | Average | Cell density (cells/mL) |
| 25*C control | 1 :4 | 31 | 29 | 31 | 25 | 29 | 1160000 |
| 37*C control | 1 :4 | 13 | 16 | 16 | 16 | 15.25 | 610000 |
| 37*C 10mM NH4 | 1 :4 | 14 | 11 | 10 | 7 | 10.5 | 420000 |
| 37*C 1mM NH4 | 1 :4 | 16 | 15 | 12 | 11 | 13.5 | 540000 |
Results: The choanos clearly recovered from the NH4. At this point it looks like the temperature difference is more detrimental to growth than NH4.
Picked colonies for iGEM10_011
Picked 8 colonies and ran a Col PCR with standard Col PCR MM (caa998 + G00101)
PCR Gel Results:
Expected size: 3700bp

- lanes 3-8 look perfect
- Colonies 1-2 are cotransformed.
To miniprep: iGEM10_011 #3,4
Miniprepped iGEM10_006 #1-5
Note: Vortexed briefly after adding P2, which may cause some contamination with genomic DNA.
Assembly of iGEM10_007
Digestion
- iGEM10_001 a - did standard Xho/Bam digestion
- iGEM10_006 #1-5:
- digested all 5 minipreps; this digestion will serve as both analytical and practical.
- made a master mix: 20uL H20, 5uL NEB2, 5uL each of Bgl and Xho
- mixed 7uL of mastermix with 4uL of each miniprep
I decided to gel purify the gels, since I was running a gel. Expected sizes:
- iGEM10_006: 6994, 1608
- iGEM10_001: 2810, 1196
Conor McClune 20:08, 20 July 2010 (EDT)
Reassembly of iGEM10_011
iGEM10_011 once again did not grow, so I suspect my digestion of iGEM10_008 may be bad and should be redone.
Digestion
Did a standard Xho/Bam digestion of iGEM10_008d and gel purified the larger part (2.5kb)
Ligation
Ligated my gel purified fragment with Amy's gel purified Xho/Bgl digestion of Bjh2294.
Transformation
Cell mixture: 100uL jtk030 cells, 30uL kcm, 50uL h20.
I added 90uL of this mixture to my ligation mixture, incubated for 1hr and plated the entire solution on a CA plate.
Picking Colonies for iGEM10_006 Eco/Bam Transfer into KA
Only five colonies grew, so I picked all 5. I swiped each colony on an AKC plate to check for cotransformation, and dipped it in a colony PCR mix containing the oligos igemTen10 and TH313.
PCR Gel Results
Expected size: 1808
Incorrect Size: 800

- all five parts appear to be in the correct vector.
- None of the colonies were cotransformed
Miniprep of iGEM
I miniprepped iGEM10_004 #8 and iGEM10_010 #1-3.
note:I accidentally used Zymo tubes (which decreases yield), so I only eluted with 25uL H20
Restriction Mapping of iGEM10_004,iGEM10_005, iGEM10_010
Yesterday's Minipreps
| Lane | Part | Colony # | Vector | Enzymes | Expected Sizes | Acceptable? |
| 1 | iGEM10_004 | 8 | pMLL9-CA | Eco/Bam | 3580, 2736 | probably |
| 2 | igEM10_005 | 1 | pMLL8-KC | Eco/Bam | 2662, 2163 | yes |
| 3 | igEM10_005 | 5 | pMLL8-KC | Eco/Bam | 2662, 2163 | yes |
| 4 | igEM10_005 | 6 | pMLL8-KC | Eco/Bam | 2662, 2163 | yes |
| 5 | igEM10_005 | 8 | pMLL8-KC | Eco/Bam | 2662, 2163 | yes |
Today's Minipreps
| Lane | Part | Colony # | Vector | Enzymes | Expected Sizes | Acceptable? |
| 1 | iGEM10_004 | 8 | pMLL9-CA | Eco/Bam | 3580, 2736 | probably |
| 2 | igEM10_010 | 1 | pMLL8-KC | Eco/Bam | 2662, 1314 | yes |
| 3 | igEM10_010 | 2 | pMLL8-KC | Eco/Bam | 2662, 1314 | yes |
| 4 | igEM10_010 | 3 | pMLL8-KC | Eco/Bam | 2662, 1314 | yes |
Conor McClune 15:37, 19 July 2010 (EDT)
Sequence Confirmation of iGEM10_006 #3
I sequenced iGEM10_006 #3 with the reverse oligo igemTen008. This part does not quite reach the junction I was trying to make. I will try sequencing it again using igemTen003.
Eco/Bam Transfer of iGEM10_006 #3
Digestion
4uL H20, 4uL DNA, 1uL Eco, 1uL Bam, 1uL NEB2. Digested from 11:05-12:10
I also needed to digest more pMLL6-KA, since our stock is empty. to do this, I mixed 10uL miniprepped DNA (containing pMLLKA) with 10uL H20, 2.5uL NEB2, 1.25uL Eco, 1.25 Bam. Digested from 1:49-2:23
Gel Purification
Expected bands:
- iGEM10_006
- desired - 5700
- undesired - 2800
- pMLL6-KA
- desired - 2877
- undesired - 324
Zymo purified the desired products. Eluted iGEM10_006 with 8.5 uL water, and pMLL6-KA with 20uL water
Ligation
Standard ligation procedure and recipe.
Assembly of iGEM10_011
No colonies grew up for iGEM10_011, so I have to re-assemble it. I already have a gel purified
Picking Colonies for iGEM10_004 and iGEM10_010
- No colonies grew up for iGEM10_011.
- 8 Colonies picked from each plate.
- iGEM10_010 colonies dipped in a colony PCR MM with oligos ca998 and G00101
- iGEM10_004 colonies dipped in two Col PCR MM:
- ca998 and G00101
- igemTen10 and TH313
- cotransformation plate reveals that iGEM10_004 colonies #1 and #4 are cotransformed
| Lanes | Part | Vector | Fwd Oligo | Rev Oligo | Expected Size | Acceptable Lanes |
| 1 to 8 | iGEM10_004 | pMLL9-CA | ca998 | G00101 | 3771 | 8 (possibly) |
| 9 to 16 | iGEM10_004 | pMLL9-CA | igemTen10 | TH313 | 1808 | 9,12,16 |
| 17 to 24 | iGEM10_010 | pMLL8-KC | ca998 | G00101 | 1505 | 17-19,21-24 |
to miniprep: iGEM10_004 #8, iGEM10_010 #1-3
Conor McClune 16:00, 16 July 2010 (EDT)
Assembly of iGEM10_010-11
Digestion:
iGEM10_009 and iGEM10_008 are already digested and gel purified
- used methylated 2:1 diluted minipreps of Bjh2294 and sbb10
- recipe:8uL DNA, 4uL water, 1uL NEB2, 1uL each enzyme
- digested sbb10 with Xho/Bam, digested Bjh2294 with Xho/Bgl
- digested from 12:50-1:40
Ligation
- Recipe: 6.5uL H20, 1uL each DNA, 1uL T4 Buffer, 1uL Ligase
- I ligated the following combinations using the above digestions and stored digestions from my freezer box:
| Part 1 | Part 2 | Product |
| sbb10 | iGEM10_009 | iGEM10_010 |
| iGEM10_008 | Bjh2294 | iGEM10_011 |
| iGEM10_004 | pMLL9-CA | iGEM10_004 |
Transformation
- started with 100ul comp jtk030 cells
- added 100ul H20 and 40uL KCM
- added 70uL of cell mixture to each ligation
- conducted standard heat shock transformation with 1hr incubation
- plated iGEM10_010 on CK and iGEM10_011/iGEM10_004 on CA
Analytical PCR of iGEM10_006 #3
Well Contents: 33uL Taq MM, 1uL each oligo, 0.5uL template DNA
| Well | Part | Fwd Oligo | Rev Oligo | Expected Size | Acceptable? |
| 1 | iGEM10_006 | ca998 | igemTen004 | 1859 | yes |
| 2 | iGEM10_006 | ca998 | igemTen006 | 2225 | yes |
| 3 | iGEM10_006 | ca998 | igemTen008 | 3289 | yes |
Conor McClune 15:43, 15 July 2010 (EDT)
Picking Colonies/Colony PCR for Eco/Bam transfers (sbb18, iGEM10_004-5)
- picked 8 colonies of sbb18, iGEM10_004, iGEM10_005
- Two PCRs per colony:
- sbb18:
- ca998+G00101
- TH313+igemTen10
- iGEM10_004:
- ca998+G00101
- TH313+igemTen10
- iGEM10_005:
- ca998+G00101
- MLL2F+igemTen10
- sbb18:
- TH313 is a fwd primer out of AmpR and MLL2F is a fwd primer out of CamR
- I swiped each colony on an ACK plate to check for cotransformation
| Lanes | Part | Vector | Checking | Fwd Oligo | Rev Oligo | Expected Size | Acceptable Lanes |
| 1 to 4 | sbb18 | pMLL6-KA | part | ca998 | G00101 | 599 | 1,2,3,4 |
| 5 to 8 | sbb18 | pMLL6-KA | vector | TH313 | igemTen10 | 1939 | 1,2,3,4 |
| 9 to 16 | iGEM10_004 | pMLL9-CA | part | ca998 | G00101 | 3771 | none |
| 17 to 24 | iGEM10_004 | pMLL9-CA | vector | TH313 | igemTen10 | 1939 | 19,20,21,24 |
| 25 to 32 | iGEM10_005 | pMLL8-KC | part | ca998 | G00101 | 2354 | 25,29,30,32 |
| 33 to 40 | iGEM10_005 | pMLL8-KC | vector | MLL2F | igemTen10 | 1808 | 33,35,37,38,40 |
Miniprep/Mapping iGEM10_006
- The colonies I picked yesterday were all on the wrong plasmid (AK not KA) and the internal plasmids did not seem to bind, but I will miniprep and digest, just in case the correct part is there within the wrong plasmid. The internal plasmids I used were long (designed for Gibson) and can be finicky.
Digestion
- standard Eco/Bam digestion (4uL H20, 1uL NEB2, 4uL DNA, 1uL each enzyme)
- digested all 5 minipreps
Gel Results

Expected Sizes:5734, 2868
- ladder warping makes it difficult to be precise, but if any lanes are correct, it is lane 3
Conor McClune 14:33, 14 July 2010 (EDT)
Assembly of iGEM10_006
Picking Colonies and Colony PCR
- picking 8 colonies
- swiping on cotransformation CKA plate
- dipping each colony in two col PCR mixes:
- igemTen003+igemTen008
- checks the presence of both iGEM10_004 and iGEM10_005
- expected size:1461
- TH313+igemTen010
- checks order of Amp and Kan resistance genes in backbone
- desired (KA) size: 1939
- undesired (AK) size: 874
- igemTen003+igemTen008
- lanes 1-5: colonies 1-5 with igemTen003+igemTen008
- checks the presence of both iGEM10_004 and iGEM10_005
- expected size:1461
- no bands visible in any lane
- lanes 6-10: colonies 1-5 with TH313+igemTen010
- checks order of Amp and Kan resistance genes in backbone
- desired (KA) size: 1939
- undesired (AK) size: 874
- all colonies have undesired antibiotic configuration (KA)
- no colonies were cotransformed
Eco/Bam Transfer sbb18 into correct KA part
Digestion: Standard Eco/Bam digestion of sbb18 from Romeo, incubated for 30 minutes.
Gel Purification:
sbb18:
- desired fragment-408
- undesired fragment-2868
iGEM10_004:
- desired fragment-3580
- undesired fragment-2868
iGEM10_005:
- desired fragment-2163
- undesired fragment-2868
I cut out the desired bands, dissolved them and zymo purified them.
Ligation:
- master mix: 24uL H20, 4uL T4 buffer w/ATP, 4uL Ligase
- 8uL master mix added to 1uL of vector and 1uL part:
- sbb18 with pMLL6
- iGEM10_004 with pMLL9
- iGEM10_005 with pMLL8
Transformation:
- 100ul Lefty pir+ mc1065
- added 30uL KCM to cells
- add 70uL of cells/KCM to ligation mixture of sbb18
- 100uL jtk030 cells
- added 50uL H20 and 40uL KCM
- added 70uL of cells to ligation mixtures for iGEM10_004 and iGEM10_005
- heat shocked cells for 90 seconds
- added 100uL 2YT to each of the 3 cultures
- rescued for 45 minutes
- plated:
- sbb18 on KA
- iGEM10_004 on CA
- iGEM10_005 on CK
Conor McClune 15:45, 13 July 2010 (EDT)
Assembly of iGEM10_006
Digestion
- iGEM10_005 #3: 4uL DNA, 4uL H2O, 1uL NEB2, 1uL Xhol, 1uL Bam
- iGEM10_004 #4: 4uL DNA, 4uL H2O, 1uL NEB2, 1uL Xhol, 1uL Bgl
- incubated from 11:19-12:25
Gel Purification
- iGEM10_004 #4:
- desired fragment:4841
- other fragment:1475
- iGEM10_005 #3:
- desired fragment:3629
- other fragment:1196

I gel purified the desired fragments and zymo purified them. I accidentally used double the water (17uL), so my zymo is a little dilute and I had to modify the ligation procedure
Ligation
- 2uL digested iGEM10_004 #4
- 2uL digested iGEM10_005 #3
- 4uL H20
- 1uL T4 ligase buffer with ATP
- 1uL T4 Ligase
Transformation
- 20uL KCM added to 100uL JTK030 comp cells
- all of ligation mixture added to these cells
- sat on ice for 10 minutes
- heat shocked at 42 for 90 seconds
- rescued at 37 on shaker form 2:56-4:02
- plated entire solution on KA plate
Conor McClune 14:14, 12 July 2010 (EDT)
Eco/Bam Transfering Basic parts to correct KA vector
- used Tim's digested parts and Amy's new digest pMLL6-KA
- I eco/bam digested sbb42 for 1hr and Bjh2245 for 30 min
- created ligase MM:
- 130uL H20
- 20uL T4 ligase buffer
- 20uL Eco/Bam digested pMLL6-KA
- added 8.5uL MM to 1uL of each of the following Eco/Bam digested parts:
| Well | Ebid | Part | Strain |
| 1 | 2 | sbb09 | R |
| 2 | 4 | sbb07 | R |
| 3 | 5 | sbb06 | R |
| 4 | 7 | sbb04 | R |
| 5 | 11 | Bjh1906 | R |
| 6 | 12 | sbb19 | R |
| 7 | 19 | sbb12 | R |
| 8 | 22 | sbb10 | R |
| 9 | 23 | sbb42 | R |
| 10 | 24 | Bjh2294 | R |
| 11 | na | Bjh2245 | R |
| 12 | 7 | sbb04 | L |
| 13 | 12 | sbb19 | L |
| 15 | 22 | sbb10 | L |
| 16 | 23 | sbb42 | L |
- Transformed into the appropriate righty or lefty mc1061 pir+ strain
Restriction Mapping
- digestion master mixes- 4 H2O: 1 NEB2 : 0.5 Enzyme1 : 0.5 Enzyme1
| Well | Part | Vector | Enzymes | Expected Sizes | Acceptable? |
| 1 | sbb10 #1 | pMLL6-KA | Eco/Bam | 2868, 1035 | yes |
| 2 | sbb10 #2 | pMLL6-KA | Eco/Bam | 2868, 1035 | yes |
| 3 | sbb10 #3 | pMLL6-KA | Eco/Bam | 2868, 1035 | yes |
| 4 | sbb10 #4 | pMLL6-KA | Eco/Bam | 2868, 1035 | yes |
| 5 | iGEM10_004 #1 | pMLL8-KC | Eco/Bam | 2662, 2163 | failed digest (righty) |
| 6 | iGEM10_004 #2 | pMLL8-KC | Eco/Bam | 2662, 2163 | failed digest (righty) |
| 7 | iGEM10_004 #4 | pMLL8-KC | Eco/Bam | 2662, 2163 | failed digest (righty) |
| 8 | iGEM10_005 #6 | pMLL8-KC | Eco/Bam | 2662, 2163 | failed digest (righty) |
| 9 | sbb04 #1 | pMLL6-KA | Eco/Bam | 2868, 1797 | yes |
| 10 | sbb04 #2 | pMLL6-KA | Eco/Bam | 2868, 1797 | yes |
| 11 | Bjh2294 #1 | pMLL6-KA | Eco/Bam | 2868, 2516 | probably |
| 12 | Bjh2294 #2 | pMLL6-KA | Eco/Bam | 2868, 2516 | probably |
| 13 | iGEM10_005 #2 | pMLL9-CA | Eco/Xho | 3227, 1598 | yes |
| 14 | iGEM10_005 #3 | pMLL9-CA | Eco/Xho | 3227, 1598 | yes |
| 15 | iGEM10_005 #4 | pMLL9-CA | Eco/Xho | 3227, 1598 | yes |
| 16 | iGEM10_005 #8 | pMLL9-CA | Eco/Xho | 3227, 1598 | yes |

iGEM10_004 failed to digest because Bam does not digest righty-methylated parts. I am redoing it with an Eco/Xho digest:

| Well | Part | Vector | Enzymes | Expected Sizes | Acceptable? |
| 1 | iGEM10_004 #1 | pMLL8-KC | Eco/Xho | 4850, 1466 | too faint to see |
| 2 | iGEM10_004 #2 | pMLL8-KC | Eco/Xho | 4850, 1466 | too faint to see |
| 3 | iGEM10_004 #4 | pMLL8-KC | Eco/Xho | 4850, 1466 | looks good |
| 4 | iGEM10_005 #6 | pMLL8-KC | Eco/Xho | 4850, 1466 | looks good |
Eco/Bgl/Bam assembly of iGEM10_006, iGEM10_010, iGEM10_011
Digestion
- digestion master mixes- 4 H2O: 1 NEB2 : 0.5 Enzyme1 : 0.5 Enzyme1
| Part | Vector | Colony # or letter | Enzymes | Desired Frag | Other Fragment |
| iGEM10_005 | pMLL8-KC | 3 | Eco/Bam | 2163 | 2662 |
| sbb10 | pMLL6-KA | 1 | Eco/Bam | 1035 | 2868 |
| iGEM10_008 | pMLL5-CK | d | Eco/Bam | 1066 | 2662 |
| iGEM10_004 | pMLL9-CA | 2 | Eco/Bgl | 6307 | 9 |
| iGEM10_009 | pMLL4-AC | b | Eco/Bgl | 3015 | 9 |
| Bjh2294 | pMLL6-KA | 1 | Eco/Bgl | 5375 | 9 |
- I gel purified all the desired fragments
- note, there was no clearly visible band at 6307 in lane 4, but I cut out a larger area. The above restriction digests of iGEM10_004 suggest that it may have been better to use colony #3 or 4, not #2, as I did.
Conor McClune 22:25, 11 July 2010 (EDT)
Col PCR results of picking iGEM10_004, iGEM10_005, sbb04 and Bjh2294
- lanes 1-8 : iGEM10_004
- expected size:3771
- wrong size, most lanes seem to match the size of iGEM10_005 instead
- lanes 9-16 : iGEM10_005
- expected size:2354
- none are correct size, though lanes 1,2,4,5,6 match the size of iGEM10_004
- lanes 17-20 : sbb04
- expected size:1988
- all 4 lanes look good
- lanes 21-24 : Bjh2294
- expected size:2707
- all 4 lanes look good
Note: lanes 17-24 and final ladder are somewhat warped due to the plastic object I used to hold the gel

I must have switched the plates for iGEM10_005 and iGEM10_004 when I was picking, so I have the correct parts under the wrong labels. From this point one I will switch the iGEM10_005 and iGEM10_004 back.
Conor McClune 20:15, 10 July 2010 (EDT)
Replenish stcoks of sbb10
- miniprepped all 4 colonies I grew up (though colony #1 looks best)
Replenish stocks of sbb04 and Bjh2294 (Self Lysis Device)
- picked 4 colonies of each and transferred to KA LB
Assembly of iGEM10_004, iGEM10_005 and iGEM10_011
- no colonies grew for iGEM10_011, but a few grew up on the plates for iGEM10_004 and iGEM10_005
Conor McClune 15:02, 9 July 2010 (EDT)
Retransform Bjh2294 (self lysis device) and sbb04 for stock replentishment
- used Assembly teams methylated, 1:2 diluted stocks
- transformed 4uL of of each miniprepped DNA into 100uL jtk030 comp cells (w/ 20uL KCM).
- rescued for 1hr at 37*C
- plated entire solutions onto KA plates
Replenish stocks of sbb10
- picked 4 colonies from yesterdays transformation and placed in 3uL KA LB
- set up a Col PCR with ca998 and G00101
Col PCR results:
- expected size:1226

Results:
Colony one looks great, other colonies show faint lines.
Assembly of iGEM10_004, iGEM10_005, iGEM10_011
Digestion
- made lefty and righty digestion MM
- digested the following parts:
| Well | Part | Vector | MM | Desired Fragment | Other Fragment |
| 1 | sbb04 | pMLL6-KA | L | 3395 | 1270 |
| 2 | iGEM10_003b | pMLL5-CK | L | 2539 | 1064 |
| 3 | iGEM10_008d | pMLL5-CK | L | 2532 | 1196 |
| 4 | iGEM10_002d | pMLL4-AC | R | 1430 | 1681 |
| 5 | iGEM10_009b | pMLL4-AC | R | 1343 | 1681 |
- I gel purified the desired bands
- Amy already had gel purified a lefty (xho/bam) digest of Bjh2294
Ligation
- I did standard ligations to make the following parts:
- sbb04 + iGEM10_002 = iGEM10_004
- iGEM10_003 + Bjh2294 = iGEM10_005
- iGEM10_008 + Bjh2294 = iGEM10_011
Transformation
- I transformed iGEM10_004 and iGEM10_011 into righty pir+ mc1061
- these I plated on CA plates after an hour's rescue
- I transformed iGEM10_005 into lefty pir+ mc1061
- these I plated on a KC plate after an hour's rescue
Conor McClune 14:03, 8 July 2010 (EDT)
Assembly of iGEM10_007 and iGEM10_013
Restriction Digest of iGEM10_004,iGEM10_005 and iGEM10_011
Samples checked: iGEM10_004#7 ,iGEM10_005#1 and iGEM10_011#1
Well contents:
- 12uL miniprepped DNA
- 2uL BamHI
- 2uL EcoR1
- 1.5 NEB2
incubated at 37 for 1hr
Gel Results:

GEM10_004 #7:
- expected sizes:2756,3580
- smeared, but does not look like there are two bands
iGEM10_005 #1:
- expected sizes:2662,2163
- smeared, but it looks like there is an incorrect band around 1kb
iGEM10_011 #1:
- expected sizes:3573,2736
- smeared, second band possibly present, though faint
Analytical PCR of iGEM10_004,iGEM10_005 and iGEM10_011
| Well | Sample | Part Checked for | Fwd Oligo | Rev Oligo | Expected Size | Acceptable Band? |
| 1 | iGEM10_004 #7 | iGEM10_003 | ca998 | igemTen008 | 1164 | yes, but also a band at 300bp |
| 2 | iGEM10_004 #7 | Bjh2294 | igemTen007 | G00101 | 2607 | no |
| 3 | iGEM10_005 #1 | sbb04 | ca998 | igemTen004 | 1888 | very faint band |
| 4 | iGEM10_005 #1 | iGEM10_002 | igemTen003 | igemTen006 | 366 | no |
| 5 | iGEM10_011 #1 | iGME10_008 | ca998 | igemTen020 | 1157 | yes, but also a band at 400bp |
| 6 | iGEM10_011 #1 | Bjh2294 | igemTen019 | G00101 | 2607 | no |
- Well contents: 33uL Taq MM, 1uL each oligo, 0.5uL template DNA
- run on program 3K45
- bands in lanes 1,3,5, but not 2,4,6, indicating that none of the parts were assembled correctly. It looks like there is only the lefty half of each part in these plasmids.
Remake of basic part Sbb10 from 140L stocks
I have not been able to digest it and the Robot Assembly team has never been able to successfully use it in an assembly, so I am going to re-eco/bam it from a BioE 140L stock.
Digest: Well contents: 4uL H20, 4uL stock sbb10, 1.1uL NEB2, 1uL Eco, 1uL Bam. Digested for 1hr.
Ligation: Ligated into pMLL6 using standard procedure.
Transform:Transformed ligation mixture into 100uL jtk030 comp cells (w/ 20uL KCM).
- Rescued for 1.5 hour.
- plated entire culture on KA plate
Conor McClune 15:08, 7 July 2010 (EDT)
2AB assembly of iGEM10_007 and iGEM10_013
Failure of iGEM10_010
Due to all the cotransformations I am getting, I am going to gel purify the digestion fragments
- sbb10:
- digested with Xhol/BamH1
- expected sizes: 2633*, 1026
- iGEM10_009:
- digest with Xhol/BglII
- expected sizes: 1343*, 1681
Gel Results of yesterdays digestions:

- I gel purified the desired fragment of iGEM10_009, but it seems sbb10 was not digested well, so I will redo the digestion
Digestion
I will be redoing the digestion of sbb10 while also digesting iGEM10_004, iGEM10_005, iGEM10_011 for restriction mapping.
Sbb10
- 3uL H20
- 8uL (1/2 diluted) miniprepped DNA (lefty methylated)
- 1.5uL NEB2 + ATP
- 1uL Xhol
- 1uL BamH1
- the part is still not digested. potential problems:
- bad enzyme?
Restriction Digests
- created 24uL Eco/Bam MM
- added 6uL MM to 4uL of iGEM10_004 #7, iGEM10_005 #1, iGEM10_011 #1
Results:

iGEM10_004 #7: 2756,3580
- expected sizes:
iGEM10_005 #1:
- expected sizes:2662,2163
iGEM10_011 #1:
- expected sizes:3573,2736
Results
- unclear, though only one band seems visible. I will rerun the digestion with a higher volume of DNA
Conor McClune 17:11, 6 July 2010 (EDT)
Manual Assembly of iGEM10_004 ,iGEM10_005 ,iGEM10_010 and iGEM10_011
Picking Colonies
- picked 8 colonies of each transformation
- set up Col PCR and swiped cotransformation plate
Col PCR results:
- note, all the PCR results seem to be wrong, but many are off by the same amount, so perhaps the ladder is off
lanes 1-8:iGEM10_004 - expected size 3771
lanes 10-17: iGEM10_005 - expected size 2354

- correct bands:
- iGEM10_004: lanes 4-7, with 7 being the strongest
- 6 is cotransformed
- miniprep: 4,5,7
- iGEM10_005: lanes 1-3, 5-8
- none are cotransformed
- miniprep 1,2,3
- iGEM10_004: lanes 4-7, with 7 being the strongest
lanes 1-8:iGEM10_010 - expected size 1505

- correct bands:
- none - 100% cotransformed
lanes 1-8:iGEM10_011 - expected size 3764

- correct bands:
- lanes 1,3 (neither cotransformed)
Transformation of Bjh2294 to replenish stock
- yesterday's transformation failed, because there were no colonies
- I will redo the transformation today
Procedure:
- add 50uL H20, 30uL KCM and 2uL DNA to 150uL mc1061 competent cells
- keep on ice for 20 min
- heat shock for 90 sec at 42*C
- mixed with 200uL 2YT and rescue for 1hr
- plate on KA plate
Conor McClune 18:14, 5 July 2010 (EDT)
2AB Assembly of Parts iGEM10_007 and iGEM10_013
Digestion for Restriction Mapping and Assembly
- made 7uL lefty and righty digestion master mix
- added made double the digestion solution for parts we constructed, so I would be able to run a restriction mapping gel with half:
| Well | Part | ' | MM | Volume MM |
| 1 | sbb04 | 7-H1 | L | 7 |
| 2 | iGEM10_003b | L | 14 | |
| 3 | sbb10 | 22-A3 | L | 7 |
| 4 | iGEM10_008d | L | 14 | |
| 5 | iGEM10_002d | R | 14 | |
| 6 | Bjh2294 | 24-G10 | R | 7 |
| 7 | iGEM10_009b | R | 14 | |
| 8 | Bjh2294 | 24-G10 | R | 7 |
- incubated wells at 37 for 1hr
- zymo purified each of the wells
- used one uL of each purified digest for ligation
- combined wells:
- 1 with 5 (to make iGEM10_004)
- 2 with 6(to make iGEM10_005)
- 3 with 7(to make iGEM10_010)
- 4 with 8(to make iGEM10_011)
- combined wells:
Restriction Digest
- digested with lefty MM (Xhol/BamHI)
- iGEM10_003b - expected sizes:2671,1064
- iGEM10_008d - expected sizes:2664,1064
- digested with righty MM (Xhol/BglII)
- iGEM10_002d - expected sizes:1681, 1430
- iGEM10_009b - expected sizes:1681, 1343

Results: The strongest bands fit the desired bands. It looks like all these parts are good, though there are some other junk bands.
Retransformation of Bjh2296
- our first stock of Bjh2296 was getting low, so I retransformed it in mc1061
- note: 2YT used for rescue may be contaminated
- plated on KA plate
Conor McClune 14:45, 4 July 2010 (EDT)
2AB construction of iGEM10_007 and iGEM10_013
Results from yesterdays Col PCR of iGEM10_004 and iGEM10_011
- iGEM10_004 - expected size: 3771
- iGEM10_011 - expected size: 3764
Results:
None of the col PCR fragments are the correct size for either of the parts.
Next Steps:
- do restriction digest to make sure the parts I am combining are correct
- redo 2AB assembly
Conor McClune 16:41, 3 July 2010 (EDT)
2AB construction of iGEM10_007 and iGEM10_013
Picking colonies
- picked 8 colonies each for iGEM10_004 and iGEM10_011
- swiped each colongy on a AMp/Cam/Kan plate to check for cotransformation
- ran 4K col pcr
Conor McClune 20:13, 2 July 2010 (EDT)
2AB construction of iGEM10_007 and iGEM10_013
- problem: yesterday I plated the two lefty cultures (containing parts iGEM10_004 and iGEM10_011) on KA plates rather than CA plates. Luckily I had saved the digestions from yesterday, so I religated and retransformed
Picking Colonies
- picked 4 colonies each from the plates containing iGEM10_005 and iGEM10_010
- swiped each colony on a cotransformation plate (Amp) after dipping in col PCR solution and 2uL KC media
Col PCR
- lanes 1-4: iGEM10_010 -expected size is 1500
- lanes 5-8: iGEM10_005 -expected size is 2350
- none of the colonies for either part are the right size. Both colonies need to be repicked
Repicking Colonies
- picked 8 more colonies each of iGEM10_010 and iGEM10_005
- ran a col PCR on COL4K
- swiped each colony on an Amp plate to check for cotransformation
Results
- all 8 colonies of iGEM10_010 are cotransformed
- Gel results of col PCR for iGEM10_005 (expected size 2350):
Choano Assays
- on Tuesday(3 days ago), I split choanos 1:15 into choano media under the following conditions:
- 25*C(control)
- 37*C incubator
- 37*C with shaking
- 1mM NH4
- 10mM NH4
- results were unconclusive, because even in the control choano density was too low for counts to be reliable, and florescence was too dim to see
Conor McClune 13:34, 1 July 2010 (EDT)
2AB assembly for iGEM10_007 and iGEM10_013
| ' | Lefty | ' | Righty | ' | Product |
| Part | Version | Part | Version | ||
| iGEM10_007 | |||||
| sbb04 | n/a | iGEM10_002 | d | iGEM10_004 | |
| iGEM10_003 | a | Bjh2294 | n/a | iGEM10_005 | |
| iGEM10_013 | |||||
| sbb10 | n/a | iGEM10_009 | b | iGEM10_010 | |
| iGEM10_008 | d | Bjh2294 | n/a | iGEM10_011 |
Digestion
- made up 35uL of lefty and righty MM
- mixed 4 uL of sbb04,iGEM10_003b,sbb10,iGEM10_008d each with 7uL lefty MM
- mixed 4 uL of iGEM10_002d,Bjh2294,iGEM10_009,Bjh2294 each with 7uL righty MM
- incubated for 1hr at 37*C
Ligation
- in each ligation: 6.5uL H2O, 1uL ligation buffer, 0.5uL ligase, 1uL lefty DNA, 1uL righty DNA
- Transformed into 70uL lefty and righty cells (parts 004 and 011 into lefty strain, and parts 005 and 010 into righty strain).
- plated lefty strains on CA and righty strains on KC plates
Analytical PCR of iGEM10_020
- Well contents: 33uL Taq/DMSO MM, 1uL template DNA, 1uL each oligo
- program: 4K55
| Well | Part | fwd oligo | reverse oligo | best annealing temp | parts tested for: | expected size |
| 1 | iGEM10_020a | ca56 | igemTen022 | 55 | igem10_001 and igem10_017 | 1800 |
| 2 | iGEM10_020a | igemTen021 | G00101 | 55 | igem10_016 and Bjh2294 | 3500 |
| 3 | iGEM10_020b | ca56 | igemTen022 | 55 | igem10_001 and igem10_017 | 1800 |
| 4 | iGEM10_020b | igemTen021 | G00101 | 55 | igem10_016 and Bjh2294 | 3500 |
- iGEM10_020b is complete


























